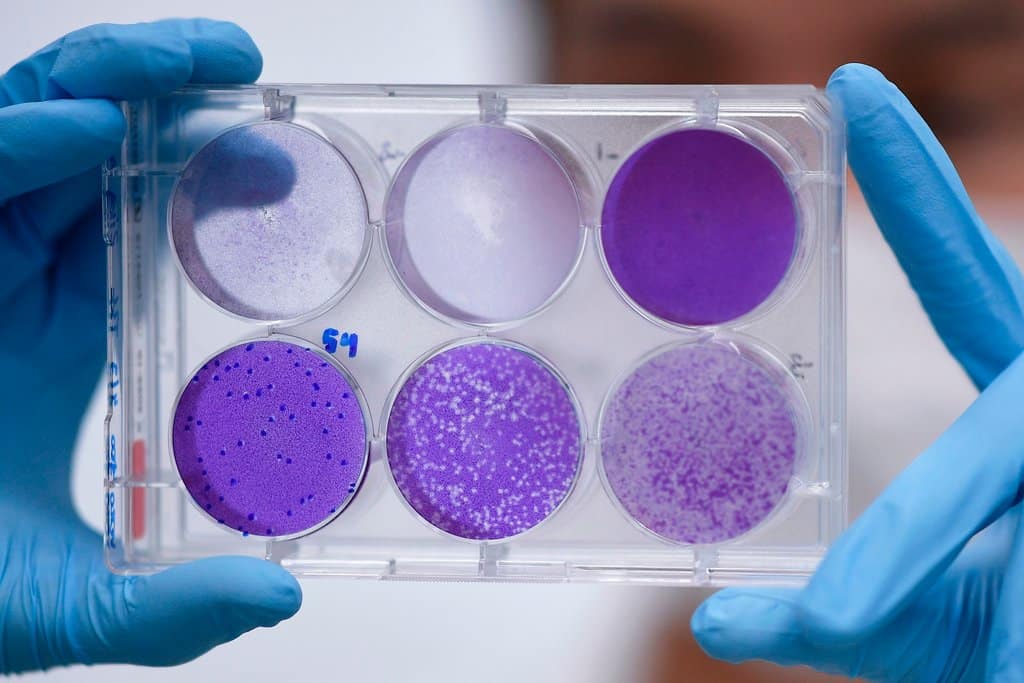

Trung Quốc được xem là một trong những nước đang dẫn đầu cuộc đua phát triển vắc xin phòng Covid-19 với 4 công ty đã thử tiến hành thử nghiệm vắc xin trên người. Tuy nhiên, vấn đề lớn đặt ra là chất lượng của những loại vắc xin đang được phát triển “siêu tốc” của nước này.
Xuất phát từ mong muốn bảo vệ người dân và làm lệch hướng chỉ trích quốc tế liên quan đến các phản ứng với dịch bệnh, Trung Quốc đã “bật đèn xanh” và hỗ trợ cho nhiều công ty dược phẩm nước này đẩy nhanh tốc độ phát triển vắc xin phòng Covid-19. Bốn công ty tại Trung Quốc đã thử nghiệm vắc xin Covid-19 trên người, nhiều hơn cả Mỹ và Anh cộng lại.
Tuy nhiên, một số chuyên gia y tế nước ngoài cũng bày tỏ lo ngại về chất lượng của vắc xin sản xuất bởi Trung Quốc. 2 năm trước, nhiều bậc phụ huynh tại nước này đã nổi cơn thịnh nộ sau khi họ phát hiện con cái mình bị tiêm loại vắc xin không đạt chuẩn chất lượng. Nhiều người dân Trung Quốc cũng có xu hướng lựa chọn vắc xin do nước ngoài sản xuất hơn là trong nước.
“Nhiều người Trung Quốc hiện không tin tưởng vào các loại vắc xin được sản xuất ở trong nước. Đây có lẽ là vấn đề làm “đau đầu” các công ty dược phẩm Trung Quốc. Nếu không có một số sự cố xảy ra, có lẽ người dân sẽ xếp hàng dài cả cây số để được tiêm ngừa vắc xin Covid-19 sau khi được sản xuất thành công”, Ray Yip, người quản lý Quỹ từ thiện Bill & Melinda Gates tại Trung Quốc, nhận xét.
Phòng thí nghiệm của một công ty dược phẩm tại Trung Quốc (ảnh: NY Times)
Vắc xin cho Covid-19 là rất cần thiết trong bối cảnh hơn 240.000 người đã tử vong do virus trên toàn thế giới. Nhiều chuyên gia cho rằng, dịch bệnh sẽ không thể chấm dứt hoàn toàn nếu không có vắc xin.
Trung Quốc đang phải hứng nhiều chỉ trích và cáo buộc đến từ một số quốc gia, đặc biệt là từ Mỹ, liên quan đến việc xử lý dịch bệnh. Nếu có thể đi đầu trong cuộc đua vắc xin, Trung Quốc có thể lấy lại uy tín của mình và gây dựng hình ảnh một cường quốc về công nghệ y tế toàn cầu.
Sản xuất vắc xin Covid-19 hiện là một trong những ưu tiên hàng đầu hiện nay tại Trung Quốc. Nước này không cung cấp số liệu chính thức về chi phí sản xuất vắc xin. Một quan chức y tế cấp cao tại Trung Quốc cho biết, vắc xin Covid-19 có thể được sử dụng khẩn cấp vào tháng 9 tới.
Các công ty dược phẩm có vốn đầu tư nhà nước chiếm khoảng 40% ngành công nghiệp vắc xin tại Trung Quốc. Vì thế, nếu chẳng may có sản phẩm lỗi bị phát hiện, những công ty này cũng có thể không bị xử phạt.
Huang Shiyue, sinh viên trường y năm nhất tại Vũ Hán – một trong những người tham gia vào thử nghiệm vắc xin Covid-19, cho biết, cô bị chóng mặt và bị ốm sau khi được tiêm vắc xin.
Huang kể lại, 15 phút sau khi được tiêm vắc xin thử nghiệm, cô bắt đầu cảm thấy chóng mặt. Bụng đau nhói, tim đập nhanh và sau đó là tiêu chảy. Huang sau đó cảm thấy ổn hơn khi được về nghỉ ngơi tại nhà.
Covid-19 được sao chép để nghiên cứu vắc xin (ảnh: NY Times)
Vắc xin mà Huang tiêm đang được phát triển bởi công ty CanSino Biologics. Đây là công ty dược phẩm đầu tiên bước vào thử nghiệm vắc xin Covid-19 giai đoạn 2 tại Trung Quốc. CanSino Biologics đã thử nghiệm vắc xin Covid-19 trên 508 người, vượt xa nhiều đối thủ khác trong cuộc đua phát triển vắc xin trên thế giới.
Năm 2018, một vụ bê bối vắc xin lớn đã xảy ra tại Trung Quốc. Công ty sản xuất vắc xin Trường Sinh, thành phố Trường Xuân (tỉnh Cát Lâm), đã bị phạt số tiền lên tới 1,3 tỷ USD vì hành vi làm giả hồ sơ, dùng các hoạt chất đã hết hạn để sản xuất vắc xin.
Hàng loạt quan chức tại Trung Quốc cũng bị sa thải do có liên quan đến sự kiện này. Trong đó, có 4 quan chức thuộc Cục Quản lý Thực phẩm và Dược phẩm Trung Quốc.
Trong nghiên cứu công bố trên tạp chí Vaccine , nhóm chuyên gia Mỹ cho biết, họ đã phân tích hơn 11.000 bình luận trên mạng xã hội Weibo và phát hiện người dân Trung Quốc đã giảm niềm tin và cảm thấy lo ngại đối với những loại vắc xin do các công ty trong nước sản xuất kể từ sau vụ bê bối năm 2018.
“Niềm tin của công chúng là rất quan trọng. Nếu mọi người không muốn tiêm vắc xin hay tệ hơn là cho rằng vắc xin có thể gây hại, không hiệu quả thì họ sẽ tìm cách trì hoãn hoặc từ chối. Loại vắc xin được chứng minh an toàn và hiệu quả nhất cũng sẽ trở nên vô dụng nếu người dân không chịu sử dụng”, David Broniatowski, chuyên gia y tế tại Đại học George Washington (Mỹ), cho biết.

Công ty dược phẩm Sinovac Biotech đang phát triển vắc xin Covid-19 tại Trung Quốc cũng từng dính vào bê bối hối lộ. Bất chấp điều này, Trung Quốc vẫn phê duyệt cho Sinovac Biotech đẩy nhanh tốc độ thử nghiệm vắc xin.
Ding Sheng, trưởng khoa dược tại Đại học Tsinghua, Bắc Kinh cho rằng, một số công ty dược phẩm tại Trung Quốc đã áp dụng các phương pháp độc đáo trong giai đoạn nghiên cứu và thử nghiệm để đẩy nhanh tốc độ phát triển vắc xin Covid-19.
“Tôi hiểu được sự mong mỏi của mọi người đối với vắc xin. Tuy nhiên, theo quan điểm khoa học, dù có sốt sắng đến đâu, chúng ta cũng không thể hạ thấp tiêu chuẩn về an toàn”, ông Ding Sheng trả lời phỏng vấn của tờ Nhân dân Nhật báo.
Theo Dân Việt

No comments.
You can be the first one to leave a comment.